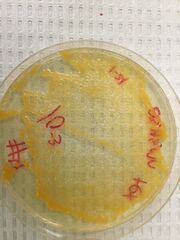
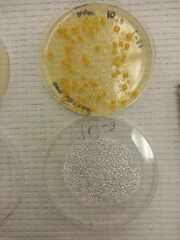

Uploads by Eliza B
From OpenWetWare
Jump to navigationJump to search
This special page shows all uploaded files.
| Date | Name | Thumbnail | Size | Description |
|---|---|---|---|---|
| 15:03, 21 March 2015 | Screen4.png (file) |  |
61 KB | |
| 15:03, 21 March 2015 | Screen5.png (file) |  |
76 KB | |
| 14:57, 21 March 2015 | Screen3.png (file) |  |
63 KB | |
| 14:56, 21 March 2015 | Screen2.png (file) |  |
43 KB | |
| 14:56, 21 March 2015 | Screen1.png (file) |  |
147 KB | |
| 14:49, 18 February 2015 | Themchains.JPG (file) |  |
61 KB | |
| 14:45, 18 February 2015 | Bug3.JPG (file) |  |
46 KB | |
| 14:42, 18 February 2015 | Vertebrate.png (file) |  |
47 KB | |
| 14:42, 18 February 2015 | Bugtable.png (file) |  |
45 KB | |
| 01:44, 11 February 2015 | Red1.jpg (file) |  |
90 KB | |
| 01:44, 11 February 2015 | Live1.jpeg (file) |  |
80 KB | |
| 01:43, 11 February 2015 | Grass1.jpg (file) |  |
50 KB | |
| 17:38, 7 February 2015 | 111.JPG (file) |  |
26 KB | |
| 17:30, 7 February 2015 | 12345.JPG (file) |  |
81 KB | |
| 17:23, 7 February 2015 | Spore.JPG (file) |  |
48 KB | |
| 17:23, 7 February 2015 | Shot1.png (file) |  |
84 KB | |
| 17:18, 7 February 2015 | Smallleaf.JPG (file) |  |
46 KB | |
| 17:17, 7 February 2015 | Purpleaf.JPG (file) |  |
50 KB | |
| 17:17, 7 February 2015 | Purple.JPG (file) |  |
151 KB | |
| 17:16, 7 February 2015 | Purpcell.JPG (file) |  |
35 KB | |
| 17:16, 7 February 2015 | Monkleaf.JPG (file) |  |
54 KB | |
| 17:16, 7 February 2015 | Monkeysm.JPG (file) |  |
166 KB | |
| 17:15, 7 February 2015 | Monkey.JPG (file) |  |
81 KB | |
| 17:15, 7 February 2015 | Monkcell.JPG (file) |  |
25 KB | |
| 17:15, 7 February 2015 | Liveleaf.JPG (file) |  |
81 KB | |
| 17:14, 7 February 2015 | Live.JPG (file) |  |
182 KB | |
| 17:13, 7 February 2015 | Deadleaf.JPG (file) |  |
89 KB | |
| 17:11, 7 February 2015 | Dead.JPG (file) |  |
181 KB | |
| 17:07, 7 February 2015 | Bread.JPG (file) |  |
20 KB | |
| 03:04, 3 February 2015 | 9tc2.JPG (file) |  |
51 KB | |
| 03:04, 3 February 2015 | 9tc.JPG (file) |  |
46 KB | |
| 03:03, 3 February 2015 | 9nc.JPG (file) |  |
57 KB | |
| 03:03, 3 February 2015 | 3tc.JPG (file) |  |
20 KB | |
| 03:03, 3 February 2015 | 3nc.JPG (file) |  |
84 KB | |
| 02:58, 3 February 2015 | 3nwm.JPG (file) |  |
45 KB | |
| 02:58, 3 February 2015 | 9ncwet.JPG (file) |  |
47 KB | |
| 02:50, 3 February 2015 | 9tet.JPG (file) |  |
38 KB | |
| 02:49, 3 February 2015 | 7tet.JPG (file) |  |
39 KB | |
| 02:49, 3 February 2015 | 5tet.JPG (file) |  |
39 KB | |
| 02:49, 3 February 2015 | 3tet.JPG (file) | |
36 KB | |
| 02:48, 3 February 2015 | Tray9.JPG (file) | |
38 KB | |
| 02:48, 3 February 2015 | Tray7.JPG (file) |  |
113 KB | |
| 02:47, 3 February 2015 | Tray5.JPG (file) |  |
93 KB | |
| 02:47, 3 February 2015 | Tray3.JPG (file) |  |
71 KB | |
| 02:44, 3 February 2015 | 1Table1.JPG (file) |  |
96 KB | |
| 02:42, 3 February 2015 | Table1.JPG (file) |  |
88 KB | |
| 02:19, 3 February 2015 | Jarside.JPG (file) |  |
47 KB | |
| 02:18, 3 February 2015 | Jargross.JPG (file) |  |
38 KB | |
| 02:18, 3 February 2015 | Jartop.JPG (file) |  |
50 KB | |
| 01:04, 29 January 2015 | ThingforIt.JPG (file) |  |
28 KB |